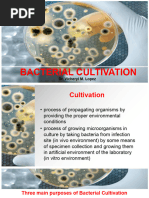

0% found this document useful (0 votes)
132 views7 pagesMicrobio Notes
The document discusses media preparation, sterilization techniques, and aseptic technique for growing bacteria in pure culture. It explains that bacteria require an artificial environment with controlled temperature, pH, gases and nutrients. Culture media can be liquid, solid, or semisolid and used for general growth, selection, differentiation or enrichment. Proper preparation includes dissolving ingredients, adjusting pH, adding agar, dispensing, and sterilization. Aseptic technique prevents contamination during inoculation and subculturing. Colonial morphology is described by texture, transparency, color and shape over time. Staining techniques identify bacterial morphology and arrangement.
Uploaded by
PrezyCopyright
© © All Rights Reserved
We take content rights seriously. If you suspect this is your content, claim it here.
Available Formats
Download as PDF, TXT or read online on Scribd
0% found this document useful (0 votes)
132 views7 pagesMicrobio Notes
The document discusses media preparation, sterilization techniques, and aseptic technique for growing bacteria in pure culture. It explains that bacteria require an artificial environment with controlled temperature, pH, gases and nutrients. Culture media can be liquid, solid, or semisolid and used for general growth, selection, differentiation or enrichment. Proper preparation includes dissolving ingredients, adjusting pH, adding agar, dispensing, and sterilization. Aseptic technique prevents contamination during inoculation and subculturing. Colonial morphology is described by texture, transparency, color and shape over time. Staining techniques identify bacterial morphology and arrangement.
Uploaded by
PrezyCopyright
© © All Rights Reserved
We take content rights seriously. If you suspect this is your content, claim it here.
Available Formats
Download as PDF, TXT or read online on Scribd
/ 7